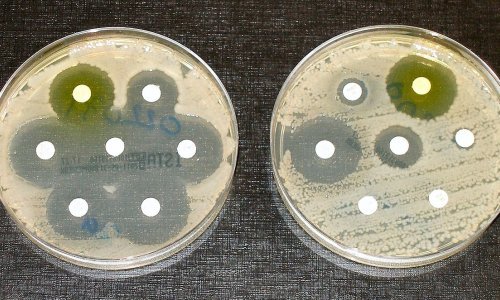

Znanstvenici su upotrijebili umjetnu inteligenciju (AI) kako bi otkrili novi antibiotik koji može ubiti smrtonosnu vrstu superbakterije, prenosi u četvrtak BBC.
AI je pomogao suziti tisuće potencijalnih kemikalija na svega nekoliko za testiranje u laboratoriju.
Rezultat je ispao potentni, eksperimentalni antibiotik zvan abaucin, kojemu će trebati daljnja testiranja prije nego što se počne koristiti.
Istraživači u Kanadi i SAD-u kažu da AI ima moć uvelike ubrzati otkriće novih lijekova.
To je posljednji u nizu primjera kako alati umjetne inteligencije mogu biti revolucionarna snaga u znanosti i medicini.
Antibiotici ubijaju bakterije, no nedostatak je novih lijekova već desetljećima, a bakterije postaje sve teže liječiti, kako stvaraju otpor na postojeće lijekove.
Godišnje umre više od milijun ljudi od infekcija koje odolijevaju liječenju antibioticima.
Istraživači su se fokusirali na jednu od najproblematičnijih vrsta bakterija - Acinetobacter baumannii - koja može inficirati rane i uzrokovati upalu pluća.
Radi se o jednoj od tri superbakterije koje je Svjetska zdravstvena organizacija identificirala kao "kritičnu" prijetnju.
Često ne reagira na razne antibiotike i problem je za bolnice i staračke domove, gdje može preživjeti na površinama i medicinskoj opremi.
Liječnik Jonathan Stokes, sa sveučilišta McMaster, opisuje bakteriju kao "javnog neprijatelja broj jedan" i kaže kako je vrlo često otporna na gotovo svaki antibiotik.
Sljedeći korak je usavršavanje lijeka u laboratoriju i potom provođenje kliničkih ispitivanja. Očekuje da bi prvi antibiotici u čijem će razvoju pomoći AI mogli stići 2030.
Zanimljivo je da ovaj eksperimentalni antibiotik nije imao učinka na druge vrste bakterija i djeluje samo na A. baumannii.
Mnogi antibiotici ubijaju bakterije bez razlike. Istraživači vjeruju da će preciznost abaucina otežati pojavu rezistencije na lijekove i dovesti do manje nuspojava.